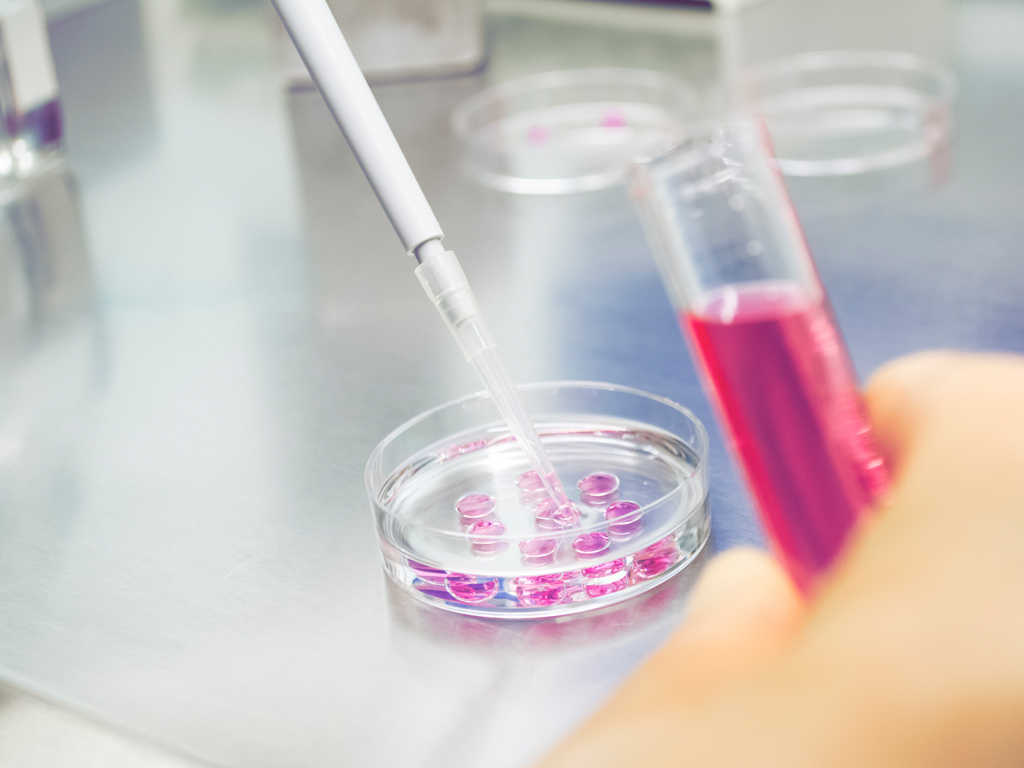

Accepting Using a Donor Egg
by Melissa Estes, LPC, LMFT
_Can I love a child I am not genetically connected to_? Will that child love me once they know?
It can be devastating for a woman to learn that she can’t use her own egg to have a baby. For a couple, it can be hard to accept that their baby won’t be, genetically, their child. These worries are common when weighing up donor conception.
These anxieties are also completely normal, and don’t indicate that a woman is likely to reject or find it hard to love a child conceived by egg donation. Often, grief at not being able to have the child you hoped for gives way to excitement, knowing that modern medicine has provided another way to add to your family.
Still, overcoming the disappointment of not being able to use your own eggs isn’t easy. Often, people experience the five stages of grief before accepting the use of a donor. Grieving is a personal process, and there is no “right way” to grieve. But if you can reach a point of acceptance, there are many benefits to using donor eggs.
Using Donor Eggs Is Common
These days in vitro fertilization (IVF) is so common that the stigma has virtually vanished; many people feel comfortable sharing that they went through IVF. But donor-egg IVF is a different story.
According to the U.S. Centers for Disease Control and Prevention, a substantial 12 percent of all IVF cycles in the U.S., about 16,000 a year, involve eggs retrieved from a donor. Donor-egg IVF has the highest success rate of any fertility treatment. Yet few women admit to going this route.
For one mom going through donor-egg IVF, the process was a chance to improve the odds and embrace change: “Each cycle has a better chance of success than when we cycled with my eggs; we won’t be doing the same thing and … getting the same results,” she said. “I’ve changed my mind before about acceptable ways for us to build a family and I can do so again.”
Anxieties About Donor Eggs Are Natural
Often, people trying to have a baby using a donor egg are anxious and have many questions. Let’s take some of the most common questions one by one:
Will the baby really feel like my own biological baby? What if we never bond? Studies have shown that when parents of donor-conceived children are asked about their experiences, they are relentlessly upbeat. Of course, it’s easy to assume those parents have to stay positive because they’re living with that choice.
But according to reproductive endocrinologist Dr. Barbara Stegmann, in the 15 years she has been working in womans health she has never encountered a patient that used a donor egg and didn’t feel like the baby was biologically theirs.
For the woman, it helps to reflect on the fact that her body gives the baby life. What she does to her body affects the baby; she will feel the baby kicking in the middle of the night; she will give birth to the baby. Pregnancy and childbirth create powerful bonding moments for mother and baby.
Will I be able to know anything about the donor who donates the egg to us? When using a donor egg from an egg donor bank, people are able to find out specific information about the donor like eye color, hair color, education, and more. Sometimes people can even see pictures of the donor throughout the donor’s life.
How would I talk to our baby about how he or she was conceived? How will the news affect him or her? Many couples choose to explain to their children that they were conceived by using an egg donor. It can help parents to feel like there is honesty in their relationships with their children. Many children’s books can help explain to a child how he or she was conceived using a donor egg.
Overcoming the Fear
Even when you have all the evidence, you might still hesitate to commit to trying to get pregnant using a donor egg. How much does genetics really matter?
The truth is that genetics is often a narrative. We use it selectively to strengthen a story we have already decided to tell. We pick out the facts that fit and ignore those that don’t.
A mother named Kami explained how using a donor egg gave her the chance to reframe the entire experience of creating a child.
“Here is a pearl from what we have gone through trying to conceive a viable baby and from my recent grief in dealing with letting go of my biological child,” said Kami. “I can choose to heal my childhood wounds before our child is born; I can be more aware of my subconscious motivations and, perhaps, be better at avoiding them; I can let go of how our child is supposed to be long before the child is who she is.” If you have concerns about egg donation, it can help to seek counseling from a professional. The Donor Conception Network is a great resource for people wanting to learn more about egg donation.
“We’re very happy this technology was available,” said new mother Wendy Kennedy a day after the birth of their daughter via donor-egg IVF. “If it weren’t for this, we wouldn’t have Avery. She’s beautiful.” In the end, love really is the only thing that matters.
If you would like to know more about using a donor egg, please contact us—we would love to hear from you.
About the Author
Melissa Estes, LPC, LMFT, is the counselor at Aspire Fertility clinic in Houston, TX. She is a licensed professional counselor and a licensed marriage and family therapist. She studied psychology at Texas A&M University and earned her masters in marriage and family therapy from the University of Houston-Clear Lake. Melissa is active in the community as well. She has been interviewed by local TV and radio programs, including Great Day Houston. She has also assisted in teaching counseling techniques to counseling students.
